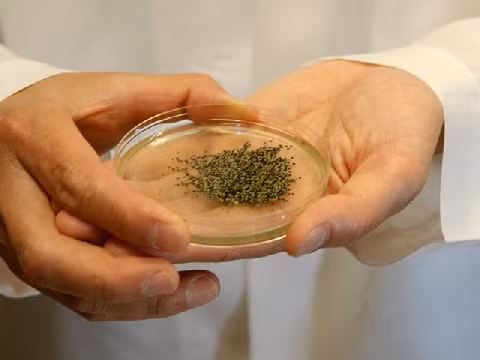
Vị của trứng muỗi được người ta mô tả là ngọt ngọt, cay cay, hơi chua chua chứ không béo ngậy như trứng kiến. Ảnh: googleusercontent.

Volkswagen Sagitar S khởi điểm từ 79.800 Nhân dân tệ (khoảng 279 triệu đồng) tại Trung Quốc, chỉ bằng một nửa so với Jetta tiêu chuẩn nhưng trang bị "xịn sò".





Volkswagen Sagitar S khởi điểm từ 79.800 Nhân dân tệ (khoảng 279 triệu đồng) tại Trung Quốc, chỉ bằng một nửa so với Jetta tiêu chuẩn nhưng trang bị "xịn sò".

Cầu Trần Hưng Đạo đang chạy đua hoàn thành trước mùa lũ 2026, đối mặt với vướng mắc mặt bằng, pháp lý và biến động thị trường vật liệu.

Từ thời internet ADSL đến kỷ nguyên Wi-Fi 7, router TP-Link giá rẻ đã âm thầm phủ sóng hàng triệu gia đình Việt, trở thành thiết bị “quốc dân” suốt hai thập kỷ.

Việc Tiêu Tường - đệ nhất mỹ nhân Đài Loan một thời góp mặt trong Đạp gió 2026 gây chú ý. Hiện tại, cô khiến Trang Pháp và nhiều thí sinh khác phải "dè chừng".

Nằm bên dòng sông Adda yên bình ở miền Bắc nước Ý, Crespi d’Adda là một ngôi làng công nghiệp độc đáo phản ánh một giai đoạn lịch sử xã hội châu Âu.

Phiên bản nâng cấp của Mercedes EQS 2027 sẽ được trang bị công nghệ lái điện tử (steer-by-wire), đi kèm với thiết kế vô lăng ngang gây nhiều ý kiến trái chiều.

Từ cậu bé chạy việc vặt, Chris Espinosa trở thành nhân viên lâu năm nhất của Apple và sở hữu tài sản hơn 114 triệu USD nhờ một triết lý đơn giản.

Kia vừa ra mắt mẫu Seltos 2027 với truyền động hybrid tại Triển lãm Ô tô New York 2026, Mỹ, đánh dấu bước thay đổi quan trọng của dòng SUV cỡ nhỏ này.
![[INFOGRAPHIC] GOOJODOQ Thumb Camera, máy ảnh “bé bằng ngón tay cái”](https://cdn.kienthuc.net.vn/images/fc6b1457645b26575fcbba0a62d9d7d4476a1f92759ad82fae515412c144ef530b1b119e2407468958b75c0eb4503acf088947e84f80275d5dc1fc397d394dc6/info-4-mayanh-02.jpg.avif)
GOOJODOQ Thumb Camera không phải là một chiếc máy ảnh để “chụp đẹp”, mà là một món phụ kiện kể chuyện bằng cảm xúc.

Chiếc Rolls-Royce Cullinan 2025 này được đưa về nước vào năm ngoái bởi một đại lý kinh doanh xe tư nhân tại Hà Nội. Mới đây, nó đã được rao bán trên sàn xe cũ.

Samsung Galaxy S26 Ultra cho thấy kỷ nguyên smartphone gây “wow” đã qua, khi giá trị flagship giờ nằm ở hiệu năng dài hạn và AI “vô hình”.

Gắn với biệt danh "cá sấu chúa", Quỳnh Nga "lột xác" ngoạn mục trở thành mỹ nhân quyến rũ của Vbiz.

Nhỏ bé, dễ nuôi và mang bộ gen gần gũi với con người, chuột nhắt bạch tạng đã trở thành “trợ thủ” không thể thiếu trong các phòng thí nghiệm.

Xem tử vi hàng ngày, tử vi 12 con giáp hôm nay cho thấy tuổi Hợi làm việc theo nhịp độ riêng và có thể trúng thưởng khi mua vé xổ số.

Trong loạt hình mới, Ninh Dương Lan Ngọc lựa chọn thiết kế ôm sát, kết hợp chất liệu mềm và xuyên thấu nhẹ, tôn lên đường nét cơ thể.

Từng được quy hoạch thành "lá phổi xanh" phía Nam Hà Nội, khu sinh thái Vĩnh Hưng nay hoang hóa, xuống cấp, trở thành khoảng đất bị lãng quên giữa lòng đô thị.

Mẫu xe SUV lớn nhất Teramont nhà Volkswagen tại thị trường Mỹ được làm mới toàn diện với không gian nội thất rộng và cao cấp hơn, công suất tăng nhẹ.

Địa hình núi hiểm trở, lực lượng phòng thủ đông đảo và UAV khiến mọi kịch bản đổ bộ của Mỹ trở nên rủi ro.

Xiaomi TV Stick HD Gen 2 lộ diện toàn cầu với Google TV, HDR10+, Dolby Audio và hiệu năng CPU tăng 38% so với đời cũ.

Jaguar XKSS 1957 - mẫu xe gắn liền với Steve McQueen, thuộc nhóm hiếm nhất lịch sử chỉ sản xuất giới hạn 16 chiếc, đi kèm hiệu năng ấn tượng.